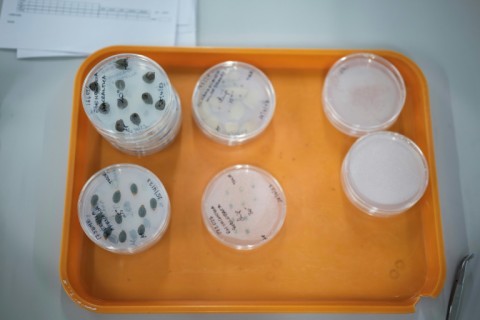

ARDINGLY - Inside bomb-proof frozen vaults underneath the English countryside hides a treasure trove of 40,000 species of wild plant seeds from around the world, many of which are in danger of disappearing.
The world's largest seed bank, located in the sleepy countryside south of London, is in a race against time because two out of five plant species are threatened with extinction, according to scientists.
Britain's David Attenborough, a leading environmental figure of international renown, has called the Millennium Seed Bank (MSB) "perhaps the most significant conservation initiative ever".
"The purpose is conservation of wild species through seeds, against those species becoming extinct, in the long run," explained John Dickie, the project's senior research leader.
The 70-year-old has been involved with the MSB since its inception in the late 1990s and the opening of its current home in 2000 to celebrate the millennium.

A total of 2.5 billion seeds are stored at the MSB in Wakehurst, 35 miles (56 kilometres) outside London, and at a branch of the capital's Kew Gardens botanical gardens.
They come in all shapes, colours and sizes, and belong to 40,020 different species originating from 190 countries.
Nearly 20 percent of the world's flora is preserved at Wakehurst, with priority given to plants that are threatened, particularly by climate change, and endemic plants that can only be found in one geographical area.
Plants that have a societal function, such as for medical or economic use, also have their place.
- 'Not rocket science' -
"Plant species are endangered for a number of reasons but mainly through land use change, and increasingly through climate change," said Dickie.
"Some plants will adapt. Others are not adaptable. At least they are here rather than not existing anymore," he added.
Wakehurst receives new seeds from all over the world every week and then the process of saving them begins.
That process is "based on the technology that has already been in use for crop species", said Dickie.
"It's not rocket science. Dry it, freeze it. It's just chemistry," he added, explaining that, once frozen, the seeds can be stored for decades, probably centuries.
Dickie's team of around 20 researchers and various volunteers works in public view in their glass-fronted laboratory.

Lucy Taylor is working on Albizia Polyphylla seeds that have arrived from Madagascar.
"Madagascar is a very interesting place for us. As it was disconnected from Africa, there's a unique flora. And there's also a lot of pressure on land," she said.
One of her jobs is to separate the empty seeds from the rest.
- Iran regrets -
"Many of them can be empty or infested with bugs or some kind of disease, so it's important for us to clean them as much as we can," explained Taylor.

"We want to have the best quality collection possible but also space in our bank vault is limited."
The seeds are X-rayed for diseases, and each is given its own identity card, with its name, country of origin and date of arrival at the MSB.
The seeds are then stored in glass jars before scientists -- kitted up like Arctic explorers -- take them to the minus 20 degree Celsius (minus four-degree Fahrenheit) underground vaults, built to withstand floods, bombings and radiation.
The largest collection of seeds is from the orchid family.
But there are also rare plants, such as the world's smallest water lily and the Deschampsia Antarctica, also known as Antarctic hair grass, one of two flowering plants native to the frozen continent.

The MSB, which receives public funding and donations, has partnerships with 90 countries.
Some, such as Indonesia, refuse to share their seeds with the MSB, but keep them on their territory and take responsibility for their conservation.
Others, however, seem out of reach. One of Dickie's few regrets is that he has no relationship with Iran.

